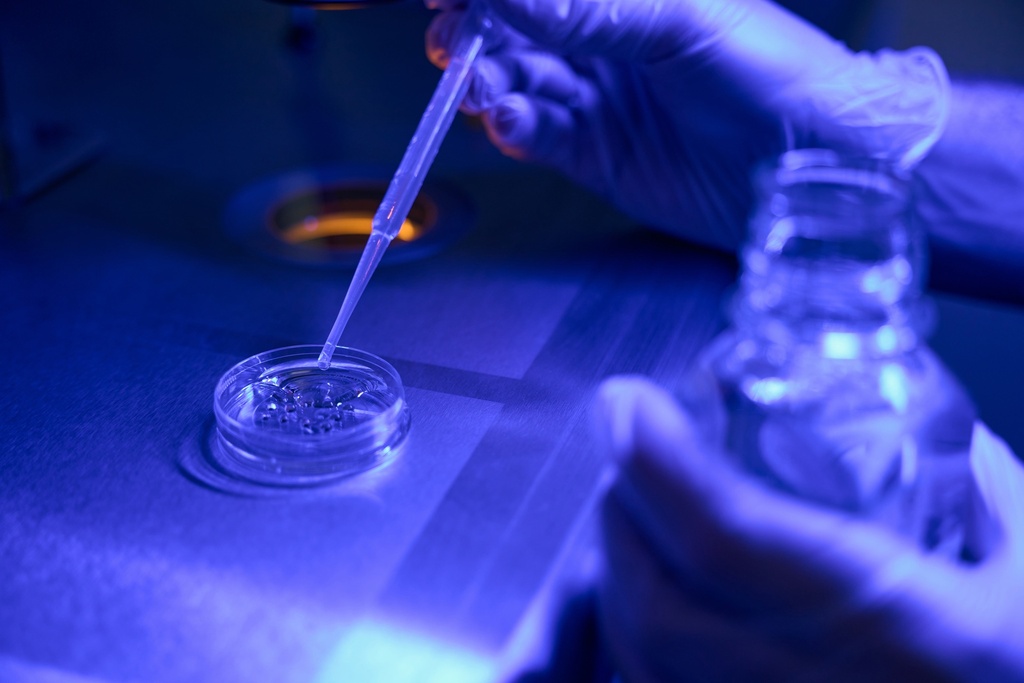
Toluene-3,5-d2 10mg

Toluene-3,5-d2 10mg
This Toluene-3,5-d2 is guaranteed a 10mg with the use of and directly supplied to your lab by Gentaur's warehouse.
Internal Reference:
RW2-TRC-T535876-10MG
Website URL:
/shop/rw2-trc-t535876-10mg-toluene-35-d2-10mg-296500